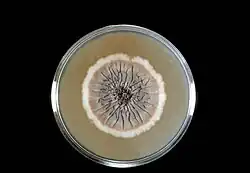

Ágar Sabouraud

O ágar Sabouraud é um tipo de ágar que contém peptonas.[1] Ele é utilizado para cultivo de dermatophytes e outros tipos de fungo, podendo ser usado também para bactérias filamentosas como Nocardia.[2][3][4]
Ele foi criado por Raymond Sabouraud em 1892. Mais tarde, Chester W. Emmons modificou a fórmula, ajustando o pH para uma concentração mais neutra e abaixando a concentração de dextrose para permitir o crescimento de mais fungos.[5] O pH de 5.6 pH do ágar Sabouraud na formulação original inibe crescimento bacteriano.
Composição típica
O ágar Sabouraud típico contém:[6]
Referências
- ↑ «Omnipresence of Microorganisms in the Environment». Consultado em 24 de outubro de 2008. Arquivado do original em 6 de outubro de 2008
- ↑ Sandven P, Lassen J (novembro de 1999). «Importance of selective media for recovery of yeasts from clinical specimens». Journal of clinical microbiology. 37 (11): 3731–2. PMC 85742
. PMID 10523586 - ↑ Guinea J, Peláez T, Alcalá L, Bouza E (dezembro de 2005). «Evaluation of Czapeck agar and Sabouraud dextrose agar for the culture of airborne Aspergillus conidia». Diagnostic microbiology and infectious disease. 53 (4): 333–4. PMID 16263232. doi:10.1016/j.diagmicrobio.2005.07.002
- ↑ About Modified Sabouraud Agar
- ↑ «History and Expected Growth» (PDF). Consultado em 4 de abril de 2015. Arquivado do original (PDF) em 19 de fevereiro de 2012
- ↑ University of Sydney, Recipes.